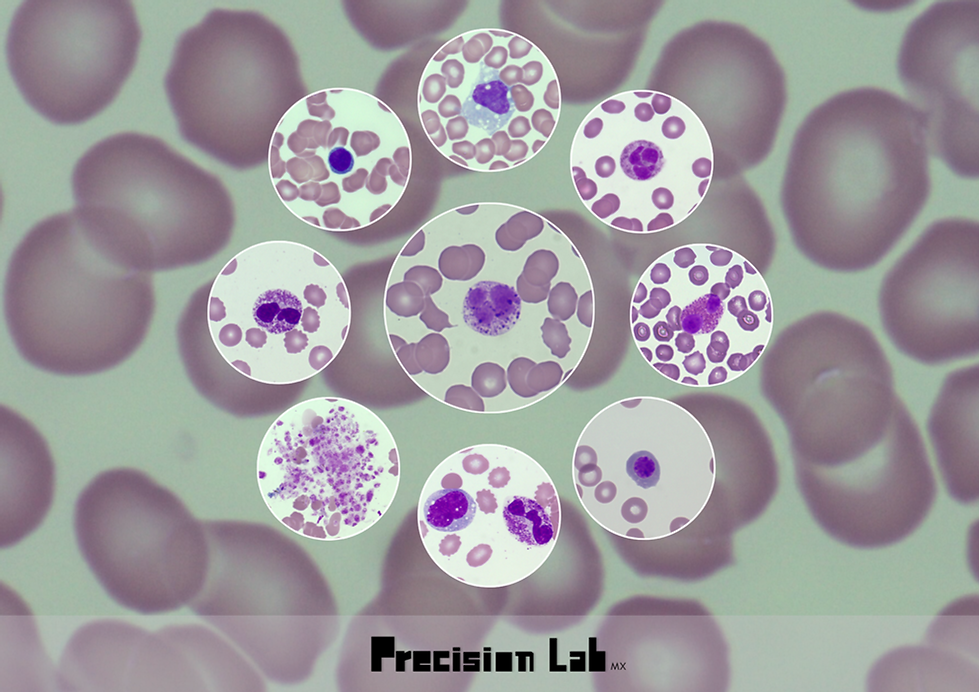
POSTER (A4 (horizontal)).png

Hemocolorante Rapido
Optimiza tus análisis con nuestro Kit de Hemocolorante Rápido. En una población normal, ofrece resultados precisos en más del 95% de los casos de forma rápida y eficiente, requiriendo únicamente la identificación de basófilos. Para el diagnóstico de leucemia, se recomienda complementar con la tinción de Wright como referencia.


¿Qué es el kit de tinción rápida? ¿Qué lo hace único?
Nuestro Kit de Tinción Rápida para Frotis Sanguíneo ofrece resultados claros y consistentes en poco tiempo, garantizando eficiencia y precisión en laboratorios clínicos.
Su fórmula optimizada permite realizar una tinción gradual, adaptándose a las necesidades de cada muestra y facilitando el control del proceso.
Esto permite ajustar la intensidad del color según el tiempo de aplicación en el mismo frotis, logrando una visualización óptima de las estructuras celulares con diferentes niveles de intensidad.
Características
🕒 Tinción rápida: resultados en solo 1 a 2 minutos.
🔬 Colores precisos: similar a la tinción de Wright, excepto en basófilos.
⚡ Uso eficiente del colorante: reduce el desperdicio gracias a su aplicación por inmersión.
📦 Mayor rendimiento: cada kit de 100 ml permite teñir entre 500 y 1000 frotis. Además, puedes ajustar la tinción en el mismo frotis sin necesidad de hacer uno nuevo.
COMPARATIVA TINCION RAPIDA-WRIGHT

).png)
TINCION GRADUAL

